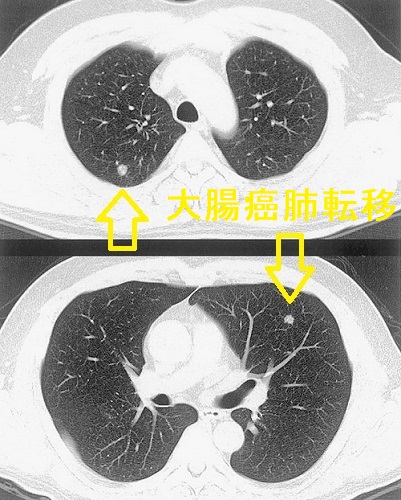
大腸癌肺転移 大腸癌肺転移
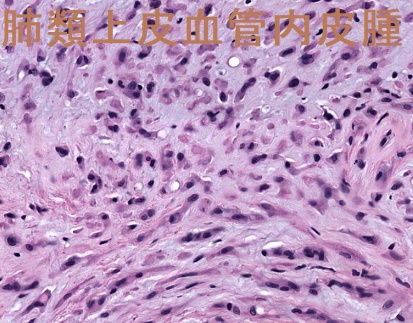
肺類上皮血管内皮腫 組織像 肺類上皮血管内皮腫 組織像

甲状腺癌の肺転移と鑑別を要する肺の病気①(肺癌,肺胞蛋白症,過敏性肺炎など)[橋本病 バセドウ病 甲状腺超音波エコー検査 長崎甲状腺クリニック 大阪]
甲状腺:専門の検査/治療/知見② 橋本病 バセドウ病 甲状腺エコー 長崎甲状腺クリニック大阪
甲状腺専門の長崎甲状腺クリニック(大阪府大阪市東住吉区)院長が海外(Pub Med)・国内論文に眼を通して得た知見、院長自身が大阪市立大学(現、大阪公立大学) 代謝内分泌内科で得た知識・経験・行った研究、年に1回、日本のどこかで開催される日本甲状腺学会で入手した知見です。
長崎甲状腺クリニック(大阪)以外の写真・図表はPubMed等において学術目的で使用可能なもの(Creative Commons License)、public health目的で官公庁・非営利団体等が公表したものを一部改変しています。引用元に感謝いたします。尚、本ページは長崎甲状腺クリニック(大阪)の経費で非営利的に運営されており、広告収入は一切得ておりません。
甲状腺・動脈硬化・内分泌代謝に御用の方は 甲状腺編 動脈硬化編 甲状腺以外のホルモンの病気(副甲状腺/副腎/下垂体/妊娠・不妊など) 糖尿病編 をクリックください。
- 甲状腺癌の肺転移・合併する肺の病気
- 甲状腺癌の肺転移と鑑別を要する肺の病気(本ページ)
長崎甲状腺クリニック(大阪)は甲状腺専門クリニックです。肺の病気の診療を行っておりません
Summary
甲状腺癌の肺転移と鑑別を要する肺の病気①肺癌自体(原発性肺がん);ほとんどの甲状腺分化癌(乳頭癌・濾胞癌)肺転移は多発小結節性だが、微小乳頭癌の肺転移は単発性、TBLBの組織染色でサイログロブリン発現せず原発性肺がんと鑑別難②甲状腺癌以外の癌からの肺転移③珪肺症;石灰化を伴うリンパ節腫大で甲状腺癌肺転移リンパ節も石灰化を伴い鑑別要④びまん性汎細気管支炎(DPB);甲状腺分化癌肺転移と比べ粒が小さい⑤肺胞蛋白症;甲状腺癌肺転移よりも大粒・集塊性④過敏性肺炎⑤急性好酸球性肺炎⑥肺類上皮血管内皮腫(EHE)。
Keywords
甲状腺癌,肺転移,びまん性汎細気管支炎,乳頭癌,濾胞癌,鑑別,肺癌,肺類上皮血管内皮腫,肺胞蛋白症,過敏性肺炎
- 鑑別を要する肺癌自体(原発性肺がん)
- 甲状腺癌以外の癌からの肺転移
- 珪肺症(けいはいしょう)
- びまん性汎細気管支炎(DPB)
- 肺胞蛋白症
- 過敏性肺炎
- 急性好酸球性肺炎
- 慢性好酸球性肺炎
- 肺類上皮血管内皮腫(EHE)
甲状腺癌の肺転移と鑑別を要する肺の病気②(感染症)
- 粟粒結核
- 誤嚥性肺炎・びまん性誤嚥性細気管支炎
- 肺ノカルジア症/脳ノカルジア症
- 侵襲性肺アスペルギルス症
- アレルギー性気管支肺アスペルギルス症(感染症と言うよりアレルギー)
- 肺犬糸状虫(フィラリア)症
- 肺吸虫症
実際のところ、甲状腺癌の肺転移か炎症性結節か鑑別できないケースは多々あります。甲状腺癌の肺転移は肺野の末梢に多いため、気管支鏡が届きにくい。血中サイログロブリン上昇に相関したサイズ増大があれば甲状腺癌肺転移の確率は高い。
甲状腺乳頭癌高細胞型(TCV)肺転移か炎症性結節か鑑別できず(CT画像)。甲状腺全摘手術後、ハイリスク群として厳格なTSH抑制療法をおこなっているため、1年後もサイズ変化なし。
甲状腺乳頭癌高細胞型(TCV)肺転移か炎症性結節か鑑別できず(CT画像)
甲状腺乳頭癌高細胞型(TCV)肺転移か炎症性結節か鑑別できず(CT画像)。
肺腺癌
原発性肺腺癌は末梢肺に発生する場合が多く、粘膜下病変主体であるため喀痰細胞診で診断できる可能性は低い。気管支鏡検査で病理組織を採取すれば確定診断できる。
肺腺癌リンパ節転移 CT画像;肺腺癌は末梢にできるため声のカスレ(嗄声、反回神経麻痺)を起こし難いですが、気管周辺の中枢測リンパ節に転移すると反回神経麻痺を生じます。
第3世代EGFRチロシンキナーゼ阻害薬のオシメルチニブ(Osimertinib:タグリッソ®)は、EGFR遺伝子変異陽性肺癌に対して高い奏効率・全生存期間の延長効果があります。しかし、重篤な有害事象として薬剤性肺障害・間質性肺炎が起こり得ます。
扁平上皮癌(肺門部肺癌、中心型肺癌)
扁平上皮癌(末梢肺癌)
甲状腺癌以外の癌からの肺転移の可能性もあります。甲状腺癌と同時に他臓器の癌(重複癌)を持っていれば可能性は高くなります。特に、多発性肺転移の形態をとる大腸がんの肺転移は紛らわしいです。
もちろんサイログロブリンなどの腫瘍マーカーも鑑別診断の参考になりますが、元々、橋本病の自己抗体の一つ抗サイログロブリン抗体(Tg-Ab)]を持っている方では、サイログロブリンが実際の値よりも低くなるため、あてになりません(抗サイログロブリン抗体(Tg-Ab) )。
大腸癌の肺転移は、肺以外に転移が無く、肺切除可能な場合は予後が良いので肺切除になります。甲状腺癌の肺転移と根本的に治療法が異なるため見逃してはいけません。
珪肺では肺の炎症に加え、肺門部、縦隔の石灰化を伴うリンパ節腫大が生じます。甲状腺癌の肺への転移リンパ節も石灰化を伴い、鑑別が必要です。実際に甲状腺癌の転移リンパ節と珪肺の炎症性リンパ節が混在した報告があります。(Auris Nasus Larynx. 2020 Dec;47(6):1054-1057.)
びまん性汎細気管支炎(DPB:diffuse panbronchiolitis)では呼吸細気管支の閉塞により残気量が増加し、閉塞性換気障害をおこします(1秒率FEV1.0%が低下)。肺胞に炎症が及ばないため、肺胞拡散能は正常です。
びまん性汎細気管支炎(DPB)は遺伝的素因が関与する可能性があり、家族内発症も報告されています。(胸疾会誌,19:645,1981.)(日胸疾会誌,20:597,1982.)
特に、橋本病(慢性甲状腺炎)、選択的IgA欠損症の免疫異常と、びまん性汎細気管支炎(DPB)を合併する母娘の報告があります(日胸疾会誌 21(5):500-506,1983.)。
正常な肺では、肺胞(空気を交換する袋)が表面張力を保ち、しぼまない様にするために肺サーファクタントが生成・分泌され、一方で、古い肺胞マクロファージが古い肺サーファクタントを分解します。
肺胞蛋白症では、分解されない肺サーファクタント由来物質が過剰に蓄積し呼吸困難に至ります。(バセドウ病、橋本病)に合併しそうなものですが、調べた限りではそのような報告はありませんでした。
顆粒球マクロファージコロニー刺激因子(GM-CSF)欠損やGM-CSF抗体などにより、肺サーファクタントを分解すべき肺胞マクロファージが未熟で機能しないためと考えられています。日本ではGM-CSF抗体による自己免疫が多いとされます。
GM-CSF抗体は自己免疫なので、自己免疫性甲状腺疾患(バセドウ病、橋本病)に合併しそうなものですが、調べた限りではそのような報告はありませんでした。
しかしながら、欧米では肺胞蛋白症にノカルジア症を合併する事が多いとされます。
過敏性肺炎(免疫過敏性肉芽腫性肺炎)は、カビ、細菌、動物性蛋白、化学物質の反復吸入によって肺胞でおきるⅢ,Ⅳ型アレルギー反応です。
- 夏型過敏性肺炎(75%):日当たり・風通しの悪い古い家屋で、高温多湿な夏にトリコスポロン(主にはトリコスポロン・アサヒ:Trichosporon asahii)というカビが繁殖するのが原因。特に土壁や観葉植物の土壌にトリコスポロンが繁殖しやすい。
抗原からの隔離が基本で、入院しても軽快しない時はステロイド投与。日当たり・風通しを良くして、こまめな清掃を行いカビを駆除する。それでも無理なら、根本的には引っ越す以外の解決方法は無い。毎年6月初旬から8月にかけて下記症状がおこる。また、木造の古い納屋を掃除した後にも同様の症状を来す。
- 農夫肺(8%):北日本の酪農家に見られ、干し草中の好熱性放線菌というカビの胞子が原因。
- 換気装置肺炎(空調肺、加湿器肺)(4%):空調や加湿器のカビを、蒸気とともに吸入するのが原因。医療機関の待合室に置いてあるのは要注意。これらは、レジオネラ肺炎の原因にもなります。
- 鳥飼病(4%):鳩やインコなど鳥類の排泄物、羽毛布団による慢性型過敏性肺炎。間質性肺炎との鑑別難。
過敏性肺炎の症状は、発熱、乾性咳嗽、呼吸困難。呼吸音は両側でfine crackles を聴取。。
過敏性肺炎の検査所見は
- Ⅲ,Ⅳ型アレルギーなので末梢血好中球増加(桿状核好中球、分葉核好中球ともに増加)、CRP陽性などの炎症所見
- 間質性肺炎;マーカーであるKL-6、SP-Dが高値。LD(LDH)も高値
- ツベルクリン反応陰転化;Ⅲ,Ⅳ型アレルギー反応による肉芽腫形成のため(サルコイドーシスと同じ)
- 肺機能検査;拘束性換気障害
- 胸部エックス線でスリガラス影
- 肺CTでは、
①小葉中心性にびまん性散在性小粒状陰影は甲状腺癌肺転移と鑑別
②モザイク状の間質性陰影(すりガラス陰影)は橋本病に合併する間質性肺炎と鑑別
- 環境誘発試験(入院中の試験外泊など)で症状が再現
- 気管支肺胞洗浄液BAL;Tリンパ球が増加(20%以上)、リンパ球分画では
①夏型過敏性肺臓炎ではCD4/CD8比低下;肉芽腫を形成するCD8 陽性T リンパ球が優位になるため
②農夫肺・鳥飼病ではCD4/CD8比が上昇
肺胞マクロファージは減少
過敏性肺炎の治療は、
- 通常プレドニゾロンですが、長期治療になるとプレドニゾロンを減量するためミコフェノール酸モフェチルやアザチオプリンなどの免疫抑制剤が必要。
- 急性期に一端、ステロイド剤、免疫抑制剤に反応しても、徐々に線維化が進行し、効きが悪くなる場合があります。進行性の線維化をともなう間質性肺疾患(慢性過敏性肺炎)にはニンテダニブの適応があります。
急性好酸球性肺炎(acute eosinophilic pneumonia)と慢性好酸球性肺炎は病態が全く異なり、別物と考えられています。急性好酸球性肺炎は、喫煙開始の早期に発症することが多い原因不明の肺炎です。受動喫煙(副流煙)でもおこります。アレルギー素因との関連は明らかでないが、タバコ煙やタバコの吸い口部分に含まれる化学物質に対するアレルギー反応と考えられます。急性好酸球性肺炎は20 ~30 歳代に好発し、男女比2:1で男性に多い。
急性好酸球性肺炎の症状は、喫煙した後の発熱、咳嗽、喀痰、呼吸困難です。喫煙は甲状腺にも悪影響を及ぼします。
- 甲状腺機能亢進症/バセドウ病の発症を誘発
- 治療開始後も抗甲状腺薬(メルカゾール、プロパジール、チウラジール)の効きを悪くする
- たとえ甲状腺機能が正常化しても、甲状腺機能亢進症/バセドウ病を再発しやすくする
(甲状腺機能亢進症/バセドウ病と喫煙)
急性好酸球性肺炎では
- 末梢血好酸球数正常のことが多い
慢性好酸球性肺炎と異なる点
回復期には増加(炎症の改善に伴い、肺の好酸球が末梢血へ移動) - 胸部CT;両側びまん性のすりガラス陰影・小葉間隔壁の肥厚・浸潤影
胸水貯留(片側性もしくは両側性) - 気管支肺胞洗浄液中の好酸球数増加(好酸球が25%以上)
- 肺生検で確定診断;著明な好酸球浸潤
[AJR Am J Roentgenol. 1996 Nov;167(5):1195-9.]
急性好酸球性肺炎の治療は
- 禁煙だけで治まらない
- 副流煙でも同様の症状が生じるため、喫煙者の近くにいかない
- 副腎皮質ステロイド投与(反応性は良好)。炎症の改善に伴い肺の好酸球が末梢血へ移動して、末梢血好酸球が一過性に増加します
急性好酸球性肺炎は、再喫煙後でも再発は少ないとされます。
慢性好酸球性肺炎は30~50 歳代の女性に好発し、喫煙とは無関係。原因不明の場合と、アレルゲン吸入が原因の場合があります。
慢性好酸球性肺炎は増悪と自然軽快を繰り返し、約30%に気管支喘息を合併。アレルギーは甲状腺機能亢進症/バセドウ病の発症・再発も誘発します。(Thyroid. 1996 Aug;6(4):349-51.)(J Clin Endocrinol Metab. 1993 Dec;77(6):1667-70.)(花粉症と甲状腺機能亢進症/バセドウ病発症・再発)
慢性好酸球性肺炎では、末梢血好酸球が高値。気管支肺胞洗浄液中の好酸球増加、経気管支肺生検で好酸球浸潤を伴った肺胞隔壁の線維化病変を認める。
慢性好酸球性肺炎の治療は、ステロイドが第一選択で著効するが、漸減中に再発。
肺類上皮血管内皮腫(EHE; Pulmonary epithelioid hemangioendothelioma)は、肺、肝、軟部組織、骨に発生する稀な腫瘍で、悪性度の報告は様々です。肺に多発性小結節を形成し、甲状腺乳頭癌の多発性肺転移を疑われる事があります。
細胞診では卵円形核を有する軽度異型細胞を認め、血管内皮由来なのでサイログロブリン(Tg)、TTF1の免疫染色陰性、血管内皮細胞マーカーのCD34 とFactor VIIIが陽性になります。(第59回 日本甲状腺学会 P2-4-4 甲状腺乳頭癌で肺に多発性小結節を伴い、肺類上皮血管内皮腫(EHE)と診断された1例)
肺類上皮血管内皮腫(EHE)は、
- ほとんどの患者で肺に限局
- 骨転移、リンパ節転移、胸膜転移(胸膜肥厚や胸水)もある(甲状腺乳頭癌肺転移の様)
- 胸部CT画像;両肺多発性結節、ほとんどが直径2.0cm未満、石灰化あり。孤立性結節はまれ(甲状腺乳頭癌肺転移の様)
- 病理組織所見;不規則な巣状構造を有する好酸性結節が、乳頭状に肺胞腔へ広がる。腫瘍細胞は小異型を伴う類上皮。免疫組織化学的には、CD34、CD31、第VIII因子およびビメンチン(VIM)陽性
- 標準治療はなく、全生存期間(OS)中央値は4.58年
[Zhonghua Jie He He Hu Xi Za Zhi. 2021 Nov 12;44(11):966-971.]
肺類上皮血管内皮腫(EHE)と甲状腺乳頭癌肺転移を合併した45歳男性の報告があります。甲状腺全摘後、放射性ヨウ素(I-131)内用療法の際、I-131シンチグラフィーで取り込み(集積)が乏しく、胸腔鏡下生検をおこないサイログロブリン・サイトケラチン陽性結節と第VIII因子陽性結節の両方を認めた。[Intern Med. 2001 Aug;40(8):772-4.]
甲状腺関連の上記以外の検査・治療 長崎甲状腺クリニック(大阪)
- 甲状腺編
- 甲状腺編 part2
- 内分泌代謝(副甲状腺/副腎/下垂体/妊娠・不妊等
も御覧ください
長崎甲状腺クリニック(大阪)とは
長崎甲状腺クリニック(大阪)は日本甲状腺学会認定 甲状腺専門医[橋本病,バセドウ病,甲状腺超音波(エコー)検査など]による甲状腺専門クリニック。大阪府大阪市東住吉区にあります。平野区,住吉区,阿倍野区,住之江区,松原市,堺市,羽曳野市,八尾市,生野区,天王寺区,東大阪市,浪速区も近く。